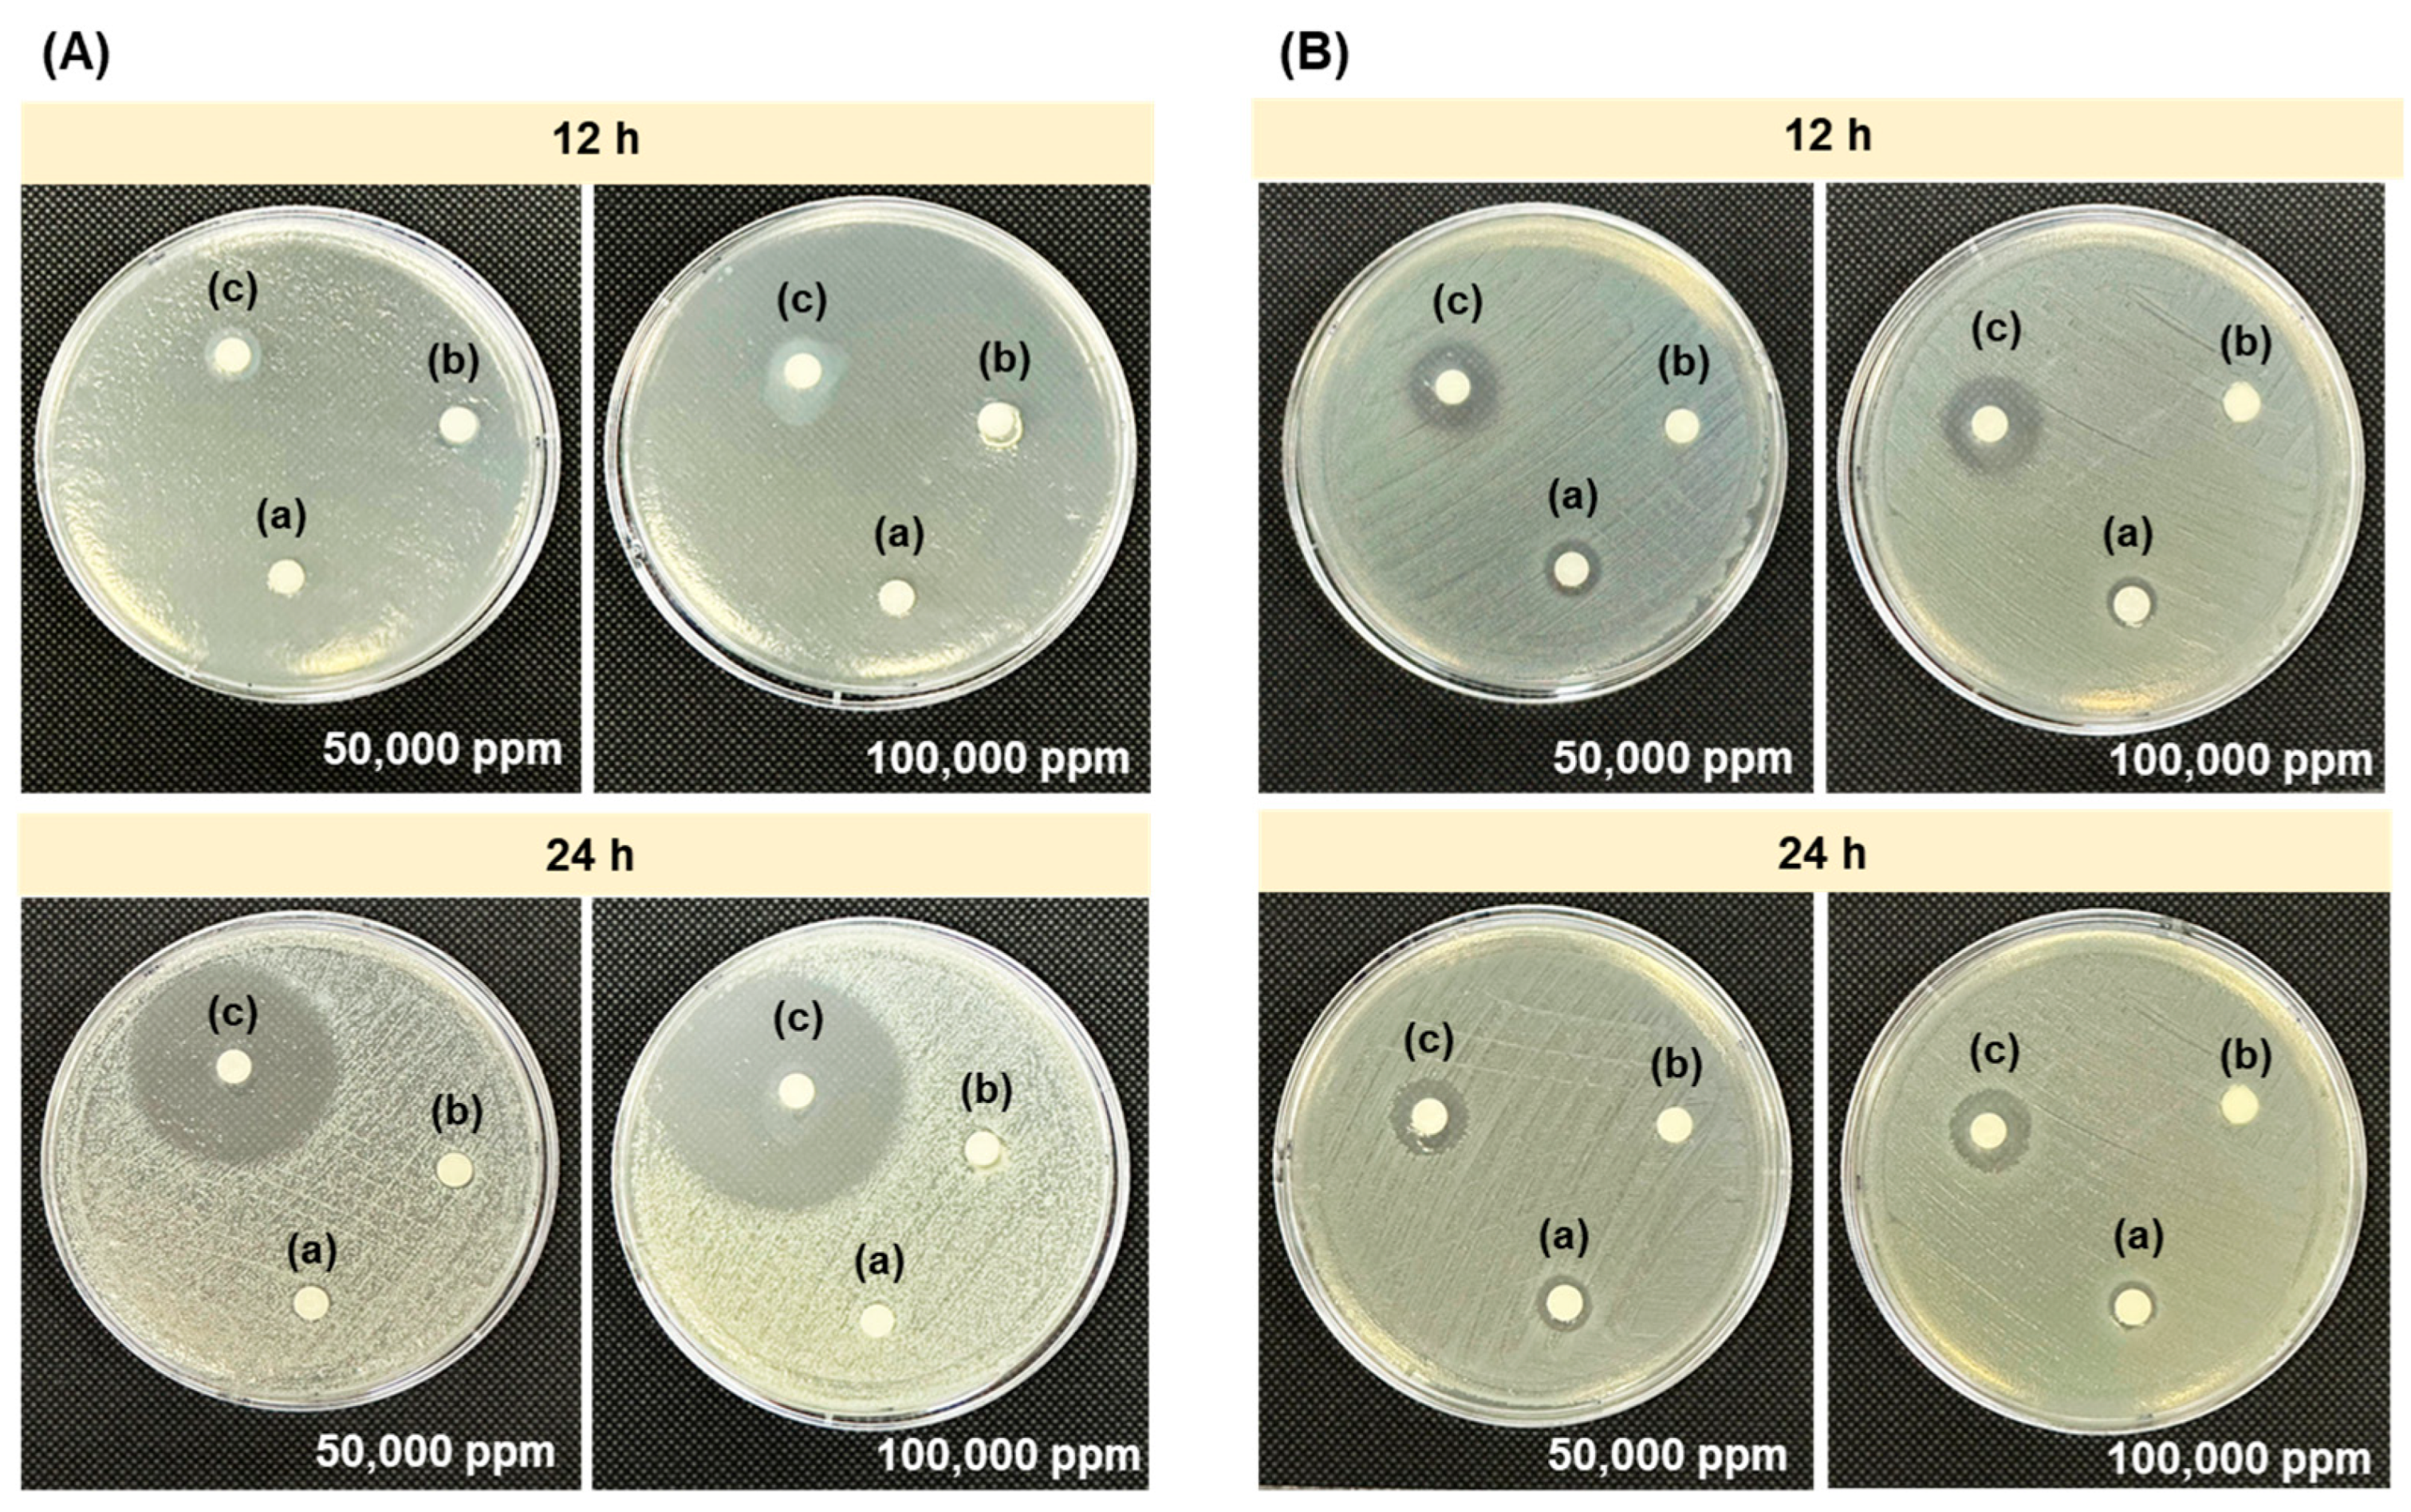

Characterization and Application of Synergistically Degraded Chitosan in Aquafeeds to Promote Immunity, Antioxidative Status, and Disease Resistance in Nile Tilapia (Oreochromis niloticus)
Abstract
1. Introduction
2. Materials and Methods
2.1. Development and Characterization of Synergistically Degraded Chitosan
2.1.1. Materials
2.1.2. Sample Preparation and γ-Irradiation Procedure
2.1.3. Characterizations of Molecular Weight by Gel Permeation Chromatography (GPC)
2.1.4. Viscosity by Rheometer
2.1.5. In Vitro Antagonistic Assay
2.2. Application of Synergistically Degraded Chitosan in Aquafeeds to Promote Immunity, Antioxidative Status, and Disease Resistance in Nile Tilapia
2.2.1. Ethics Statement
2.2.2. Animal Husbandry
2.2.3. Experimental Design
- (1)
- C (Control): basal diet top-dressed with sterile distilled water (10% w/w).
- (2)
- NCS-50: basal diet coated with high-molecular-weight chitosan at 0.5% w/w.
- (3)
- RCS-0.025: basal diet coated with degraded chitosan at 0.025% w/w.
- (4)
- RCS-0.05: basal diet coated with degraded chitosan at 0.05% w/w.
- (5)
- RCS-0.075: basal diet coated with degraded chitosan at 0.075% w/w.
2.2.4. Growth Performance Analysis
2.2.5. Collection of Whole Blood and Serum
2.2.6. qRT-PCR Analysis of Immune-Related Genes
2.2.7. Measurement of Oxidative Stress Marker and Antioxidative Enzyme Activity in Serum
- (1)
- Thiobarbituric-Acid-Reactive Substance (TBARS) Assay
- (2)
- Reduced Glutathione (GSH) Content
- (3)
- Nitric Oxide (NO) Determination
- (4)
- Glutathione Reductase (GR) Activity
- (5)
- Catalase (CAT) Activity
- (6)
- Superoxide Dismutase (SOD) Activity
- (7)
- Glutathione Peroxidase (GPx) Activity
- (8)
- Glutathione-S-Transferase (GST) Activity
2.2.8. Humoral Immune Response Assays
- (1)
- Lysozyme activity
- (2)
- Total serum IgM antibody level using a direct ELISA
- (3)
- Bactericidal activity
2.2.9. Disease Resistance and Relative Percent Survival (RPS) to E. tarda
2.2.10. Statistical and Data Analysis
3. Results
3.1. Effects of γ-Radiation Dose and H2O2 Concentration on Molecular Weight and Polydispersity Index (PDI) of Chitosan
3.2. Effects of γ-Radiation Dose and H2O2 Concentration on Viscosity of Chitosan
3.3. Effects of γ-Radiation Dose and H2O2 Concentration on Size and Surface Charge of Chitosan
3.4. In Vitro Antagonistic Activity of Chitosan Synergistically Degraded by γ-Irradiation and H2O2
3.5. Application of Synergistically Degraded Chitosan in Aquafeeds to Promote Immunity, Antioxidative Status, and Disease Resistance in Nile Tilapia
3.5.1. Growth Performance
3.5.2. Expression of Immune-Related Genes
3.5.3. Serum Oxidative Stress Marker and Antioxidative Enzyme Activity
3.5.4. Humoral Immune Responses
- (1)
- Lysozyme activity
- (2)
- Total serum IgM antibody level
- (3)
- Bactericidal activity
3.5.5. Disease Resistance and Relative Percent Survival (RPS) to E. tarda
4. Discussion
5. Conclusions
Author Contributions
Funding
Institutional Review Board Statement
Data Availability Statement
Conflicts of Interest
References
- Sukkarun, P.; Kitiyodom, S.; Kamble, M.T.; Bunnoy, A.; Boonanuntanasarn, S.; Yata, T.; Boonrungsiman, S.; Thompson, K.D.; Rodkhum, C.; Pirarat, N. Systemic and mucosal immune responses in red tilapia (Oreochromis sp.) following immersion vaccination with a chitosan polymer-based nanovaccine against Aeromonas veronii. Fish Shellfish Immunol. 2024, 146, 109383. [Google Scholar] [CrossRef]
- Tigchelaar, M.; Leape, J.; Micheli, F.; Allison, E.H.; Basurto, X.; Bennett, A.; Bush, S.R.; Cao, L.; Cheung, W.W.L.; Crona, B.; et al. The vital roles of blue foods in the global food system. Glob. Food Secur. 2022, 33, 100637. [Google Scholar] [CrossRef]
- Paankhao, N.; Sangsawang, A.; Kantha, P.; Paankhao, S.; Promsee, K.; Soontara, C.; Kongsriprapan, S.; Srisapoome, P.; Kumwan, B.; Meachasompop, P.; et al. Antioxidant and antibacterial efficiency of the ethanolic leaf extract of Kratom (Mitragyna speciosa (Korth.) Havil) and its effects on growth, health, and disease resistance against Edwardsiella tarda infection in Nile tilapia (Oreochromis niloticus). Fish Shellfish Immunol. 2024, 152, 109771. [Google Scholar] [CrossRef]
- Elgendy, M.Y.; Sherif, A.H.; Kenawy, A.M.; Abdelsalam, M. Phenotypic and molecular characterization of the causative agents of edwardsiellosis causing Nile tilapia (Oreochromis niloticus) summer mortalities. Microb. Pathog. 2022, 169, 105620. [Google Scholar] [CrossRef]
- Wright, A.; Li, X.; Yang, X.; Soto, E.; Gross, J. Disease prevention and mitigation in US finfish aquaculture: A review of current approaches and new strategies. Rev. Aquac. 2023, 15, 1638–1653. [Google Scholar] [CrossRef]
- Piekarska, K.; Sikora, M.; Owczarek, M.; Jóźwik-Pruska, J.; Wiśniewska-Wrona, M. Chitin and Chitosan as Polymers of the Future—Obtaining, Modification, Life Cycle Assessment and Main Directions of Application. Polymers 2023, 15, 793. [Google Scholar] [CrossRef]
- Kaya, M.; Seyyar, O.; Baran, T.; Erdoğan, S.; Kar, M. A physicochemical characterization of fully acetylated chitin structure isolated from two spider species: With new surface morphology. Int. J. Biol. Macromol. 2014, 65, 553–558. [Google Scholar] [CrossRef]
- Rattanawongwiboon, T.; Hemvichian, K.; Lertsarawut, P.; Suwanmala, P. Chitosan-poly(ethylene glycol) diacrylate beads prepared by radiation-induced crosslinking and their promising applications derived from encapsulation of essential oils. Radiat. Phys. Chem. 2020, 170, 108656. [Google Scholar] [CrossRef]
- Duy, N.N.; Phu, D.V.; Anh, N.T.; Hien, N.Q. Synergistic degradation to prepare oligochitosan by γ-irradiation of chitosan solution in the presence of hydrogen peroxide. Radiat. Phys. Chem. 2011, 80, 848–853. [Google Scholar] [CrossRef]
- Makuuchi, K. Critical review of radiation processing of hydrogel and polysaccharide. Radiat. Phys. Chem. 2010, 79, 267–271. [Google Scholar] [CrossRef]
- Abdel-Ghany, H.M.; Salem, M.E.-S. Effects of dietary chitosan supplementation on farmed fish; a review. Rev. Aquac. 2020, 12, 438–452. [Google Scholar] [CrossRef]
- Hossam-Elden, N.; Abu-Elala, N.M.; AbuBakr, H.O.; Luo, Z.; Aljuaydi, S.H.; Khattab, M.; Ali, S.E.; Marzouk, M.S.; Teiba, I.I. Dietary Chitosan Nanoparticles Enhance Growth, Antioxidant Defenses, Immunity, and Aeromonas veronii biovar sobria Resistance in Nile tilapia Oreochromis niloticus. Fishes 2024, 9, 388. [Google Scholar] [CrossRef]
- El-Naggar, M.; Salaah, S.; El-Shabaka, H.; El-Rahman, F.A.; Khalil, M.; Suloma, A. Efficacy of dietary chitosan and chitosan nanoparticles supplementation on health status of Nile tilapia, Oreochromis niloticus (L.). Aquac. Rep. 2021, 19, 100628. [Google Scholar] [CrossRef]
- Wiratama, N.; Meachasompop, P.; Kumwan, B.; Adisornprasert, Y.; Srisapoome, P.; Phrompanya, P.; Thangsunan, P.; Thangsunan, P.; Saenphet, K.; Saenphet, S.; et al. Dietary Probiotic Bacillus subtilis AAHM-BS2360 and Its Postbiotic Metabolites Enhance Growth, Immunity, and Resistance to Edwardsiellosis in Pangasianodon hypophthalmus. Antioxidants 2025, 14, 629. [Google Scholar] [CrossRef]
- Soontara, C.; Uchuwittayakul, A.; Kayansamruaj, P.; Amparyup, P.; Wongpanya, R.; Srisapoome, P. Adjuvant Effects of a CC Chemokine for Enhancing the Efficacy of an Inactivated Streptococcus agalactiae Vaccine in Nile Tilapia (Oreochromis niloticus). Vaccines 2024, 12, 641. [Google Scholar] [CrossRef]
- Elbahnaswy, S.; Elshopakey, G.E. Differential gene expression and immune response of Nile tilapia (Oreochromis niloticus) challenged intraperitoneally with Photobacterium damselae and Aeromonas hydrophila demonstrating immunosuppression. Aquaculture 2020, 526, 735364. [Google Scholar] [CrossRef]
- Pierezan, F.; Yun, S.; Piewbang, C.; Surachetpong, W.; Soto, E. Pathogenesis and immune response of Nile tilapia (Oreochromis niloticus) exposed to Tilapia lake virus by intragastric route. Fish Shellfish Immunol. 2020, 107, 289–300. [Google Scholar] [CrossRef]
- Thangsunan, P.; Kitiyodom, S.; Srisapoome, P.; Pirarat, N.; Yata, T.; Thangsunan, P.; Boonrungsiman, S.; Bunnoy, A.; Rodkhum, C. Novel development of cationic surfactant-based mucoadhesive nanovaccine for direct immersion vaccination against Francisella noatunensis subsp. orientalis in red tilapia (Oreochromis sp.). Fish Shellfish Immunol. 2022, 127, 1051–1060. [Google Scholar] [CrossRef] [PubMed]
- Bunnoy, A.; Thompson, K.D.; Thangsunan, P.; Chokmangmeepisarn, P.; Yata, T.; Pirarat, N.; Kitiyodom, S.; Thangsunan, P.; Sukkarun, P.; Prukbenjakul, P.; et al. Development of a bivalent mucoadhesive nanovaccine to prevent francisellosis and columnaris diseases in Nile tilapia (Oreochromis niloticus). Fish Shellfish Immunol. 2023, 138, 108813. [Google Scholar] [CrossRef] [PubMed]
- Yang, C.G.; Wang, X.L.; Tian, J.; Liu, W.; Wu, F.; Jiang, M.; Wen, H. Evaluation of reference genes for quantitative real-time RT-PCR analysis of gene expression in Nile tilapia (Oreochromis niloticus). Gene 2013, 527, 183–192. [Google Scholar] [CrossRef]
- Tsikas, D. Assessment of lipid peroxidation by measuring malondialdehyde (MDA) and relatives in biological samples: Analytical and biological challenges. Anal. Biochem. 2017, 524, 13–30. [Google Scholar] [CrossRef]
- Jollow, D.J.; Mitchell, J.R.; Zampaglione, N.; Gillette, J.R. Bromobenzene-Induced Liver Necrosis. Protective Role of Glutathione and Evidence for 3,4-Bromobenzene Oxide as the Hepatotoxic Metabolite. Pharmacology 2008, 11, 151–169. [Google Scholar] [CrossRef] [PubMed]
- Sun, J.; Zhang, X.; Broderick, M.; Fein, H. Measurement of Nitric Oxide Production in Biological Systems by Using Griess Reaction Assay. Sensors 2003, 3, 276–284. [Google Scholar] [CrossRef]
- Sahreen, S.; Khan, M.R.; Khan, R.A. Evaluation of antioxidant activities of various solvent extracts of Carissa opaca fruits. Food Chem. 2010, 122, 1205–1211. [Google Scholar] [CrossRef]
- Maehly, A.C. The Assay of Catalases and Peroxidases. In Methods of Biochemical Analysis; ASTM: New York, NY, USA, 1954; pp. 357–424. [Google Scholar]
- Takada, Y.; Noguchi, T.; Okabe, T.; Kajiyama, M. Superoxide dismutase in various tissues from rabbits bearing the Vx-2 carcinoma in the maxillary sinus. Cancer Res. 1982, 42, 4233–4235. [Google Scholar] [PubMed]
- Mohandas, J.; Marshall, J.J.; Duggin, G.G.; Horvath, J.S.; Tiller, D.J. Differential distribution of glutathione and glutathione-related enzymes in rabbit kidney: Possible implications in analgesic nephropathy. Biochem. Pharmacol. 1984, 33, 1801–1807. [Google Scholar] [CrossRef]
- Habig, W.H.; Pabst, M.J.; Jakoby, W.B. Glutathione S-transferases. The first enzymatic step in mercapturic acid formation. J. Biol. Chem. 1974, 249, 7130–7139. [Google Scholar] [CrossRef]
- Shugar, D. The measurement of lysozyme activity and the ultra-violet inactivation of lysozyme. Biochim. Biophys. Acta 1952, 8, 302–309. [Google Scholar] [CrossRef]
- Klongklaew, N.; Tansutaphanit, S.; Tiewpair, P.; Buncharoen, W.; Phaksopa, J.; Srisapoome, P.; Uchuwittayakul, A. Fish Health Enhancement and Intestinal Microbiota Benefits of Asian Seabass (Lates calcarifer Bloch, 1790) on Dietary Sea Lettuce (Ulva rigida C. Agardh, 1823) Extract Supplementation. Animals 2025, 15, 1714. [Google Scholar] [CrossRef]
- Uchuwittayakul, A.; Rodkhum, C.; Srisapoome, P. Production of a monoclonal antibody specific to the IgM heavy chain of Asian seabass (Lates calcarifer Bloch, 1790) and its application in assessing health status following vaccination and challenges with Flavobacterium covae and Streptococcus iniae. Aquaculture 2025, 594, 741445. [Google Scholar] [CrossRef]
- Uchuwittayakul, A.; Thompson, K.D.; Thangsunan, P.; Phaksopa, J.; Buncharoen, W.; Saenphet, K.; Kumwan, B.; Meachasompop, P.; Saenphet, S.; Wiratama, N.; et al. Evaluation of a hydrogel platform for encapsulated multivalent Vibrio antigen delivery to enhance immune responses and disease protection against vibriosis in Asian seabass (Lates calcarifer). Fish Shellfish Immunol. 2025, 160, 110230. [Google Scholar] [CrossRef]
- Shrivastava, A. 2—Polymerization. In Introduction to Plastics Engineering; Shrivastava, A., Ed.; William Andrew Publishing: Norwich, NY, USA, 2018; pp. 17–48. [Google Scholar]
- Vikhoreva, G.A.; Gal’braikh, L.S. Rheological properties of solutions of chitosan and carboxymethylchitin. Fibre Chem. 1997, 29, 287–291. [Google Scholar] [CrossRef]
- Savitri, E.; Juliastuti, S.R.; Handaratri, A.; Sumarno; Roesyadi, A. Degradation of chitosan by sonication in very-low-concentration acetic acid. Polym. Degrad. Stab. 2014, 110, 344–352. [Google Scholar] [CrossRef]
- Qin, C.; Li, H.; Xiao, Q.; Liu, Y.; Zhu, J.; Du, Y. Water-solubility of chitosan and its antimicrobial activity. Carbohydr. Polym. 2006, 63, 367–374. [Google Scholar] [CrossRef]
- Jeon, Y.-J.; Park, P.-J.; Kim, S.-K. Antimicrobial effect of chitooligosaccharides produced by bioreactor. Carbohydr. Polym. 2001, 44, 71–76. [Google Scholar] [CrossRef]
- Silhavy, T.J.; Kahne, D.; Walker, S. The bacterial cell envelope. Cold Spring Harb. Perspect. Biol. 2010, 2, a000414. [Google Scholar] [CrossRef]
- Rabea, E.I.; Badawy, M.E.T.; Stevens, C.V.; Smagghe, G.; Steurbaut, W. Chitosan as Antimicrobial Agent: Applications and Mode of Action. Biomacromolecules 2003, 4, 1457–1465. [Google Scholar] [CrossRef]
- Wu, Y.; Rashidpour, A.; Almajano, M.P.; Metón, I. Chitosan-Based Drug Delivery System: Applications in Fish Biotechnology. Polymers 2020, 12, 1177. [Google Scholar] [CrossRef]
- Zhang, P.; Liu, W.; Peng, Y.; Han, B.; Yang, Y. Toll like receptor 4 (TLR4) mediates the stimulating activities of chitosan oligosaccharide on macrophages. Int. Immunopharmacol. 2014, 23, 254–261. [Google Scholar] [CrossRef] [PubMed]
- Zhao, M.; Pang, S.; Gao, Y.; Li, T.; Jiang, H. Effect of Chitooligosaccharides on TLR2/NF-κB Signaling in LPS-Stimulated RAW 264.7 Macrophages. Molecules 2025, 30, 2226. [Google Scholar] [CrossRef] [PubMed]
- Linh, N.V.; Lubis, A.R.; Dinh-Hung, N.; Wannavijit, S.; Montha, N.; Fontana, C.M.; Lengkidworraphiphat, P.; Srinual, O.; Jung, W.-K.; Paolucci, M.; et al. Effects of Shrimp Shell-Derived Chitosan on Growth, Immunity, Intestinal Morphology, and Gene Expression of Nile Tilapia (Oreochromis niloticus) Reared in a Biofloc System. Mar. Drugs 2024, 22, 150. [Google Scholar] [CrossRef] [PubMed]
- Rashwan, A.G.; Assar, D.H.; Salah, A.S.; Liu, X.; Al-Hawary, I.I.; Abu-Alghayth, M.H.; Salem, S.M.R.; Khalil, K.; Hanafy, N.A.N.; Abdelatty, A.; et al. Dietary Chitosan Attenuates High-Fat Diet-Induced Oxidative Stress, Apoptosis, and Inflammation in Nile Tilapia (Oreochromis niloticus) through Regulation of Nrf2/Kaep1 and Bcl-2/Bax Pathways. Biology 2024, 13, 486. [Google Scholar] [CrossRef] [PubMed]
- Zhang, Q.; Xie, Y.; Tang, J.; Meng, L.; Huang, E.; Liu, D.; Tong, T.; Liu, Y.; Guo, Z. Effects of Dietary Chitosan on Growth Performance, Serum Biochemical Indices, Antioxidant Capacity, and Immune Response of Juvenile Tilapia (Oreochromis niloticus) under Cadmium Stress. Animals 2024, 14, 2259. [Google Scholar] [CrossRef] [PubMed]
- Chien, P.-J.; Sheu, F.; Huang, W.-T.; Su, M.-S. Effect of molecular weight of chitosans on their antioxidative activities in apple juice. Food Chem. 2007, 102, 1192–1198. [Google Scholar] [CrossRef]

| Genes | Gene Group | Primer Names | Nucleotide Sequences (5′→3′) | Tm (°C) | Reference |
|---|---|---|---|---|---|
| CC chemokines | Immune-related gene | On_cc | F: ACAGAGCCGATCTTGGGTTACTTG R: TGAAGGAGAGGCGGTGGATGTTAT | 60 | [15] |
| Interferon gamma 1 | On_ifng1 | F: CAGCAGAGATGAACTTGA R: CACTAGGAAATACGGGTTT | 60 | [15] | |
| Nuclear factor-kappa B | On_nfkb | F: AACGACGGTGATGACAACGAC R: AAATTCAGGCTCCACACTGACC | 60 | [16] | |
| Myxovirus resistance | On_mx | F: ACCCTTGAGCTGGTGAATCA R: ATCCTGAGTGAATGCGGTCA | 60 | [17] | |
| Interleukin 1 beta | On_il1b | F: GTGCTGAGCACAGAATTCCAGGAT R: GAAGAACCAAGCTCCTCTTTTGGC | 60 | [15] | |
| Tumor necrosis factor | On_tnf | F: CTGTAGTCACCTCCATTA R: TACTTGTTGTTGCTTCTG | 60 | [15] | |
| Immunoglobulin M heavy chain | On_ighm | F: GCAAGTAACCCAGTCACTAAAGTC R: AAGGTTCCCTCAAAGGCTCAAT | 60 | [18] | |
| Immunoglobulin T heavy chain | On_ight | F: CAACAGTGGCAGTTCACATCCT R: ACGTTGGTGCCTGTAACATAAC | 60 | [18] | |
| Actin beta | References/housekeeping gene | On_actb | F: ACAGGATGCAGAAGGAGATCACAG R: GTACTCCTGCTTGCTGATCCACAT | 60 | [19] |
| Elongation factor-1-alpha | On_ef1a | F: GGACACGGAAAGGATTGACAG R: GTTCGTTATCGGAATTAACCAGAC | 60 | [20] | |
| Glyceraldehyde-3-phosphate dehydrogenase | On_gapdh | F: GATAATGGCAAACTTGTCGTCG R: ACATTGGAGCATCGGGTGAG | 60 | [20] |
| Samples | H2O2 (% w/v) | Radiation Dose (kGy) | Average Molecular Weight, MW (kDa) | PDI () |
|---|---|---|---|---|
| Chitosan (DD > 95%) | 0 | 0 | 84.995 | 2.504 |
| Degraded chitosan | 0.25 | 0 | 19.372 | 2.530 |
| 5 | 19.277 | 2.520 | ||
| 10 | 13.359 | 2.426 | ||
| 20 | 12.007 | 2.503 | ||
| 0.5 | 0 | 4.571 | 1.553 | |
| 5 | 4.858 | 1.569 | ||
| 10 | 4.594 | 1.553 | ||
| 20 | 4.341 | 1.549 | ||
| 1.0 | 0 | 4.813 | 1.621 | |
| 5 | 4.570 | 1.596 | ||
| 10 | 3.975 | 1.547 | ||
| 20 | 3.600 | 1.764 |
| H2O2 (% w/v) | Average Size (nm) | |||
|---|---|---|---|---|
| 0 kGy | 5 kGy | 10 kGy | 20 kGy | |
| 0 | 2429 (0.261) | 701 (0.277) | 430 (0.429) | 370 (0.355) |
| 0.25 | 2197 (0.367) | 272 (0.352) | 224 (0.451) | 207 (0.492) |
| 0.5 | 1227 (0.456) | 278 (0.341) | 215 (0.413) | 148 (0.533) |
| 1 | 922 (0.391) | 266 (0.264) | 188 (0.285) | 137 (0.335) |
| H2O2 (% w/v) | Zeta Potential (mV) | |||
|---|---|---|---|---|
| 0 kGy | 5 kGy | 10 kGy | 20 kGy | |
| 0 | +58.8 | +42.7 | +40.7 | +39.5 |
| 0.25 | +48.4 | +42.7 | +37.6 | +34.2 |
| 0.5 | +48.8 | +38.0 | +35.1 | +35.4 |
| 1 | +39.5 | +36.5 | +33.5 | +33.4 |
| Growth Parameters | Control | NCS-50 | RCS-0.025 | RCS-0.050 | RCS-0.075 |
|---|---|---|---|---|---|
| Weight Gain; WG (g/fish) | 38.50 ± 4.4 a | 36.50 ± 2.59 a | 37.50 ± 1.18 a | 36.17 ± 3.54 a | 35.67 ± 1.41 a |
| Average Daily Gain; ADG (g/day) | 1.28 ± 0.36 a | 1.22 ± 0.46 a | 1.25 ± 0.39 a | 1.17 ± 0.27 a | 1.19 ± 0.27 a |
| Survival Rate; SR (%) | 100 a | 100 a | 100 a | 100 a | 100 a |
| Feed Conversion Ratio; FCR | 1.16 ± 0.04 a | 1.08 ± 0.01 a | 1.02 ± 0.02 a | 1.06 ± 0.13 a | 1.05 ± 0.15 a |
Disclaimer/Publisher’s Note: The statements, opinions and data contained in all publications are solely those of the individual author(s) and contributor(s) and not of MDPI and/or the editor(s). MDPI and/or the editor(s) disclaim responsibility for any injury to people or property resulting from any ideas, methods, instructions or products referred to in the content. |
© 2025 by the authors. Licensee MDPI, Basel, Switzerland. This article is an open access article distributed under the terms and conditions of the Creative Commons Attribution (CC BY) license (https://creativecommons.org/licenses/by/4.0/).
Share and Cite
Rattanawongwiboon, T.; Paankhao, N.; Buncharoen, W.; Pansawat, N.; Kumwan, B.; Meachasompop, P.; Kantha, P.; Pansiri, T.; Tangthong, T.; Laksee, S.; et al. Characterization and Application of Synergistically Degraded Chitosan in Aquafeeds to Promote Immunity, Antioxidative Status, and Disease Resistance in Nile Tilapia (Oreochromis niloticus). Polymers 2025, 17, 2101. https://doi.org/10.3390/polym17152101
Rattanawongwiboon T, Paankhao N, Buncharoen W, Pansawat N, Kumwan B, Meachasompop P, Kantha P, Pansiri T, Tangthong T, Laksee S, et al. Characterization and Application of Synergistically Degraded Chitosan in Aquafeeds to Promote Immunity, Antioxidative Status, and Disease Resistance in Nile Tilapia (Oreochromis niloticus). Polymers. 2025; 17(15):2101. https://doi.org/10.3390/polym17152101
Chicago/Turabian StyleRattanawongwiboon, Thitirat, Natthapong Paankhao, Wararut Buncharoen, Nantipa Pansawat, Benchawan Kumwan, Pakapon Meachasompop, Phunsin Kantha, Tanavan Pansiri, Theeranan Tangthong, Sakchai Laksee, and et al. 2025. "Characterization and Application of Synergistically Degraded Chitosan in Aquafeeds to Promote Immunity, Antioxidative Status, and Disease Resistance in Nile Tilapia (Oreochromis niloticus)" Polymers 17, no. 15: 2101. https://doi.org/10.3390/polym17152101
APA StyleRattanawongwiboon, T., Paankhao, N., Buncharoen, W., Pansawat, N., Kumwan, B., Meachasompop, P., Kantha, P., Pansiri, T., Tangthong, T., Laksee, S., Paankhao, S., Promsee, K., Jaroenkittaweewong, M., Lertsarawut, P., Srisapoome, P., Hemvichian, K., & Uchuwittayakul, A. (2025). Characterization and Application of Synergistically Degraded Chitosan in Aquafeeds to Promote Immunity, Antioxidative Status, and Disease Resistance in Nile Tilapia (Oreochromis niloticus). Polymers, 17(15), 2101. https://doi.org/10.3390/polym17152101

